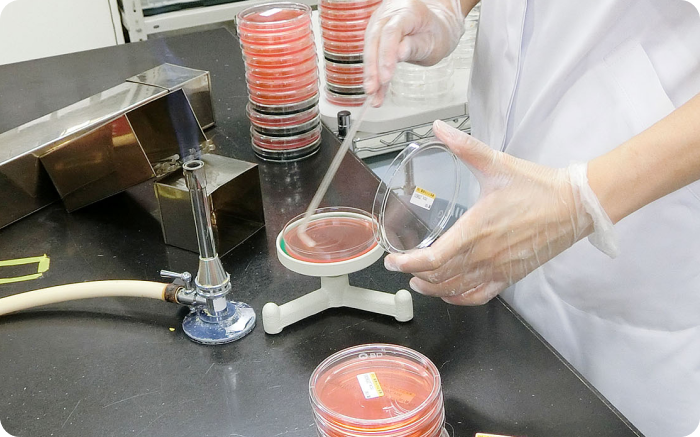
厳格なチェック体制　イメージ

01食の安心へのこだわり

QUALITA(クオリタ) は、
安心な食品をお届けする為の取り組みです。
QUALITA(クオリタ)は、インターネットを通じてギフトカタログ商品の情報をお客様に提供する「食の情報公開」、売場や製造メーカーが日々取り組む「食の安全チェック」、そして阪急クオリティーサポートが衛生管理体制をバックアップする「専門機関のサポート」。
これら3 つの取り組みを軸として、お客様に安心な食品をお届けする仕組みです。
02食の情報を公開
お客様が気になる商品の情報をお調べいただけます。
商品情報を検索する
商品情報をWeb上で管理します。
クオリタの会員となった事業者のみなさまに商品情報を登録していただき、阪急クオリティーサポートがWeb上で管理するシステムです。ご登録いただいた情報は、基準に適合しているかを審査。合格商品の情報を公開しています。
参加事業者は、加工食品の製造者、卸売業者、生鮮食品の生産者、百貨店など約800社にのぼります。
-

情報登録
原材料などの商品情報と各種検査、表示内容などをシステムデータベースへ登録します。
-

審査の実施
法律に適合していることはもちろん、お客様の立場で厳しく設定した自主品質管理基準に適合しているか、審査します。
基準に基づいて審査
独自のシステムによる
情報の集約と加工品質管理情報の発信
-

Webサイト・スマートフォン・タブレットを
通して情報を公開商品番号からの検索
アレルゲンを含まない
商品検索店名・ギフト名からの検索


商品番号から検索
このメニューでは、阪急・阪神百貨店のお中元・お歳暮などのカタログで、「QUALITA」マークが併記されている商品について商品情報をご覧いただけます。カタログに掲載されている商品番号や、受け取った商品に貼付されているお届け票に記載されている商品番号で探すことができます。
アレルゲンを含まない商品検索
このメニューでは、アレルゲンを含んでいない商品をお探しいただけます。
法令で表示の必要がない場合、「含んでいない」と表記しています。店名・ギフト名からの検索
このメニューでは、阪急・阪神百貨店のお中元・お歳暮カタログで「QUALITA」マークが併記されている商品について、「店名」や「ギフト名」で検索することで商品情報をご覧いただけます。
商品の詳細情報を確認できます。
商品情報は、消費者のみなさまに公開。アレルゲンの有無や、産地、原材料、栄養成分、添加物など、具体的な商品情報を掲載しています。ご家庭のパソコンや、スマートフォン・タブレットから、気になるアレルゲンを含まない商品を検索できるほか、ギフト名や商品番号を入力して情報を見ることが可能。
現在、約6,500点の商品情報を掲載しています。

03食の安全をチェック
長年食品の安全管理に
携わってきた歴史と
実績を持つ
阪急クオリティーサポートが、
全面的にバックアップし、
食の安全をさらに高めています。
-

取引の開始から商品の販売まで、一貫した衛生管理体制づくりを 支援する機関です。

グループで取り扱う食品の安全について、「阪急クオリティーサポート」がトータルに支援を行います。新規取引先の工場衛生点検にはじまり、食品販売前の審査、販売後の商品抜取による細菌検査、そして食にまつわる様々な情報を提供するセミナーや従業員への衛生教育まで、一貫した衛生管理体制づくりをサポートしています。
-

各分野に精通した現場のプロがサポートします。

- 徹底した品質管理を支援する阪急クオリティーサポートでは、常に一定の品質を保った商品を安全というレベルでお客様に提供できるよう、定期的に店頭商品の抜取で細菌検査を実施しています。
- 原材料やアレルゲン、栄養成分などが、法令で定められた通りに適正に表記されているかをチェックするのが表示審査です。また、新規に販売する商品に対しても取引先から提出された表示内容を確認し、信頼できる情報が提供できるよう厳しく目を光らせています。
- 新しく取引を開始する場合、事前に食品工場を訪れて製造工程や異物混入対策、施設・設備の状況、従業員の衛生管理意識などを判定するのが工場衛生点検です。独自の基準による判定表で点数を算出し、その評価点で取引の可否が決定されます。
- 取引先へのコンサルティングとして、商品抜取の細菌検査で基準から外れた商品の改善策や、ギフト商品の適正な包装などについても対応し、お客様にとっての一層の安全を追求しています。

厳格なチェック体制で様々なサポートを行っています。
阪急クオリティーサポートでは、法律で定められた細菌検査に対する基準をベースに、さらに食品に関する多様な菌の検査に対応するための自主基準を策定し、厳密な細菌検査を施しています。その厳しい細菌検査は、新しく取引する場合の納入先の商品や新しく販売する商品についても実施し、厳正なチェック体制でサポートをおこなっています。
阪急クオリティーサポートでは、法律で定められた細菌検査に対する基準をベースに、さらに食品に関する多様な菌の検査に対応するための自主基準を策定し、厳密な細菌検査を施しています。その厳しい細菌検査は、新しく取引する場合の納入先の商品や新しく販売する商品についても実施し、厳正なチェック体制でサポートをおこなっています。食品納入業者と新規取引を
行う場合
- 1食品工場や加工場に阪急クオリティーサポートがうかがい、独自の基準による判定表を用いて衛生調査をおこないます。対象となる工場は惣菜、生菓子などです。
- 2衛生調査の評価点が70点未満の場合はグループとの取引はおこなわれません。
- 3高い安全レベルをめざすため、『食品の品質管理基準』を取引間のルールとして活用していただくことを契約時に取り決めます。また、食の安全・安心を実践するための『食品の品質管理マニュアル』も併用します。
食品納入業者の新商品を
販売する場合- 1阪急クオリティーサポートが、グループ品質管理基準に適合するかどうかの審査をおこない、合格した商品のみ販売いたします。
- 2審査内容は細菌検査による「安全性」と表示ラベルに表記された「品質表示」です。「品質表示」が不適正な場合、改善の確認後に販売いたします。
阪急クオリティーサポートの
実績紹介阪急クオリティーサポートは約50年に渡り、食品安全管理に携わってきました。施設の検査・指導、商品検査、品質管理基準の作成など、豊富な経験と実績があります。なかでも全国各地の食品工場の点検数は年間500件、メーカーから納入される商品の表示の審査・検査は年間数10万件以上を実施しています。
農林水産省
フード・コミュニケーション・
プロジェクトへの参加
阪急クオリティーサポートでは、農林水産省が取り組んでいるフード・コミュニケーション・プロジェクトの理念に賛同し、積極的に参加しています。
このプロジェクトで策定された協働の着眼点(消費者の信頼を高めていくために着目すべき食品事業者の行動のポイント)を活用したセルフアセスメントシートを開発・運用し、中小規模の食品事業者が自ら食の安全・安心の課題を分析できる仕組みを確立しました。

